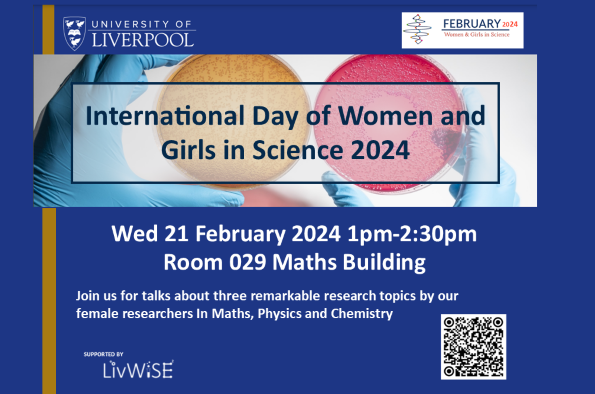

Events in February 2024

Sustainability at the Feel Good Welcome Hub
11:00am - 3:00pm / Thursday 1st February 2024
Department / Networking Event

Aerospace Engineering - Not just flying cars & rocket salad! Inaugural Lecture Prof Mike Jump
5:30pm - 6:30pm / Thursday 1st February 2024
Department / Lecture / Liverpool Women in Science and Engineering

Beyond the Troubles: Politics and Placemaking in the ‘New Northern Ireland'
6:00pm - 7:30pm / Thursday 1st February 2024
Department / Lecture

The Irish Language in Liverpool / An Ghaeilge i Learpholl
2:00pm - 3:30pm / Saturday 3rd February 2024
Department / Seminar


Alicia Boole, the Fourth Dimension & the Beginnings of the Liverpool Mathematical Society
5:00pm - 6:00pm / Wednesday 7th February 2024 / Online event
Department / Lecture / Liverpool Women in Science and Engineering

ACE Postgate Lecture: Professor Catherine Rowett'
5:15pm - 7:00pm / Tuesday 13th February 2024
Department / Lecture

Horizon Europe Cluster 5 - Climate, Energy and Mobility
2:30pm - 4:00pm / Thursday 15th February 2024
University / Webinar
International Day of Women and Girls in Science 2024
1:00pm - 2:30pm / Wednesday 21st February 2024
Department / Seminar / Liverpool Women in Science and Engineering

Guild History of Paper Talk & Craft: Sustainability Week
10:00am - 1:00pm / Monday 26th February 2024
Department / Workshop

Guided Tour of the Energy Centre: Sustainability Week
12:00pm - 1:00pm / Monday 26th February 2024
Department / Other

Sustainability in the Liverpool city region with the 2030hub: Sustainability Week
12:00pm - 12:45pm / Monday 26th February 2024 / Online event
Department / Webinar

Crosby Beach Litter Pick: Sustainability Week
1:00pm - 5:00pm / Monday 26th February 2024
Department / Other

Creative Consultants: The Power of Collaboration workshop: Sustainability Week
2:00pm - 3:00pm / Monday 26th February 2024
Department / Workshop

Green Film Showcase: WALL-E: Sustainability Week
5:00pm - 8:00pm / Monday 26th February 2024
Department / Other

Sustainability Roadshow with Faculty of Health and Life Sciences: Sustainability Week
10:00am - 12:00pm / Tuesday 27th February 2024
Department / Exhibition

Guild Street Swap Shop: Sustainability Week
10:00am - 4:00pm / Tuesday 27th February 2024
Department / Networking Event

Campus Food & Drink sustainability pop up: Sustainability Week
11:00am - 3:00pm / Tuesday 27th February 2024
Department / Exhibition

Food Pantry x Liverpool Zero Waste Community Love Food Hate Waste: Sustainability Week
11:00am - 3:00pm / Tuesday 27th February 2024
Department / Other

UoL Circular Economy Project Pop Up Shop: Sustainability Week
11:00am - 3:00pm / Tuesday 27th February 2024
Department / Exhibition

Sustainability Roadshow: Sustainability Week
12:00pm - 2:00pm / Tuesday 27th February 2024
Department / Exhibition

Guided Tour of the Energy Centre: Sustainability Week
12:00pm - 1:00pm / Tuesday 27th February 2024
Department / Other

Sustainable Laboratories/LEAF talk and Q&A: Sustainability Week
1:00pm - 2:00pm / Tuesday 27th February 2024
Department / Seminar

Science of Climate Change COP28 Briefing: Sustainability Week
1:00pm - 2:00pm / Tuesday 27th February 2024
Department / Lecture

Sustainable Laboratories/LEAF drop in: Sustainability Week
2:00pm - 3:00pm / Tuesday 27th February 2024
Department / Workshop

Guided tour: Life Sciences LEAF Labs: Sustainability Week
9:30am - 10:30am / Wednesday 28th February 2024
Department / Other

Guided tour: Life Sciences LEAF Labs: Sustainability Week
10:30am - 11:30am / Wednesday 28th February 2024
Department / Other

Campus Food & Drink sustainability pop up: Sustainability Week
11:00am - 3:00pm / Wednesday 28th February 2024
Department / Exhibition

Sustainability Roadshow with Liverpool Guild of Students: Sustainability Week
11:00am - 2:00pm / Wednesday 28th February 2024
Department / Other

Sustainability Roadshow with Liverpool Guild of Students: Sustainability Week
11:00am - 2:00pm / Wednesday 28th February 2024
Department / Other

Film Screening: Children of Men: Sustainability Week
12:00pm - 1:30pm / Wednesday 28th February 2024
Department / Other

2030 SDGs Game: Sustainability Week
2:00pm - 4:00pm / Wednesday 28th February 2024
Department / Other

Gardening with the Guild: Guild Wall: Sustainability Week
2:00pm - 4:00pm / Wednesday 28th February 2024
Department / Other

Food Pantry Love Food Hate Waste: Sustainability Week
2:00pm - 6:00pm / Wednesday 28th February 2024
Department / Other

Guided tour: LEAF Central Teaching Labs: Sustainability Week
2:00pm - 4:00pm / Wednesday 28th February 2024
Department / Other

Halls' Exclusive Green Film Showcase: Dark Waters: Sustainability Week
5:00pm - 8:00pm / Wednesday 28th February 2024
Department / Other

Inaugural Lecture - Professor Emma Boyland
5:30pm - 8:00pm / Wednesday 28th February 2024
Research / Lecture

Halls Exclusive City Bike Ride: Sustainability Week
6:00pm - 8:00pm / Wednesday 28th February 2024
Department / Networking Event

Sustainability Roadshow with Faculty of Humanities and Social Sciences: Sustainability Week
10:00am - 12:00pm / Thursday 29th February 2024
Department / Networking Event

Sustainable Labs Online Workshop: Sustainability Week
10:00am - 11:00am / Thursday 29th February 2024
Department / Networking Event

Bringing the World to Liverpool with Carol Rose Burke - MD at Unipart Manufacturing Group
12:00pm - 1:00pm / Thursday 29th February 2024
Department / Webinar

Sustainability Roadshow with Faculty of Science and Engineering: Sustainability Week
12:00pm - 2:00pm / Thursday 29th February 2024
Department / Networking Event

Guided Tour: Materials Innovation Factory: Sustainability Week
12:30pm - 1:30pm / Thursday 29th February 2024
Department / Other

Crafternoon: Upcycling T-Shirt Totes & Tin Can Plant Pots: Sustainability Week
1:00pm - 5:00pm / Thursday 29th February 2024
Department / Other
